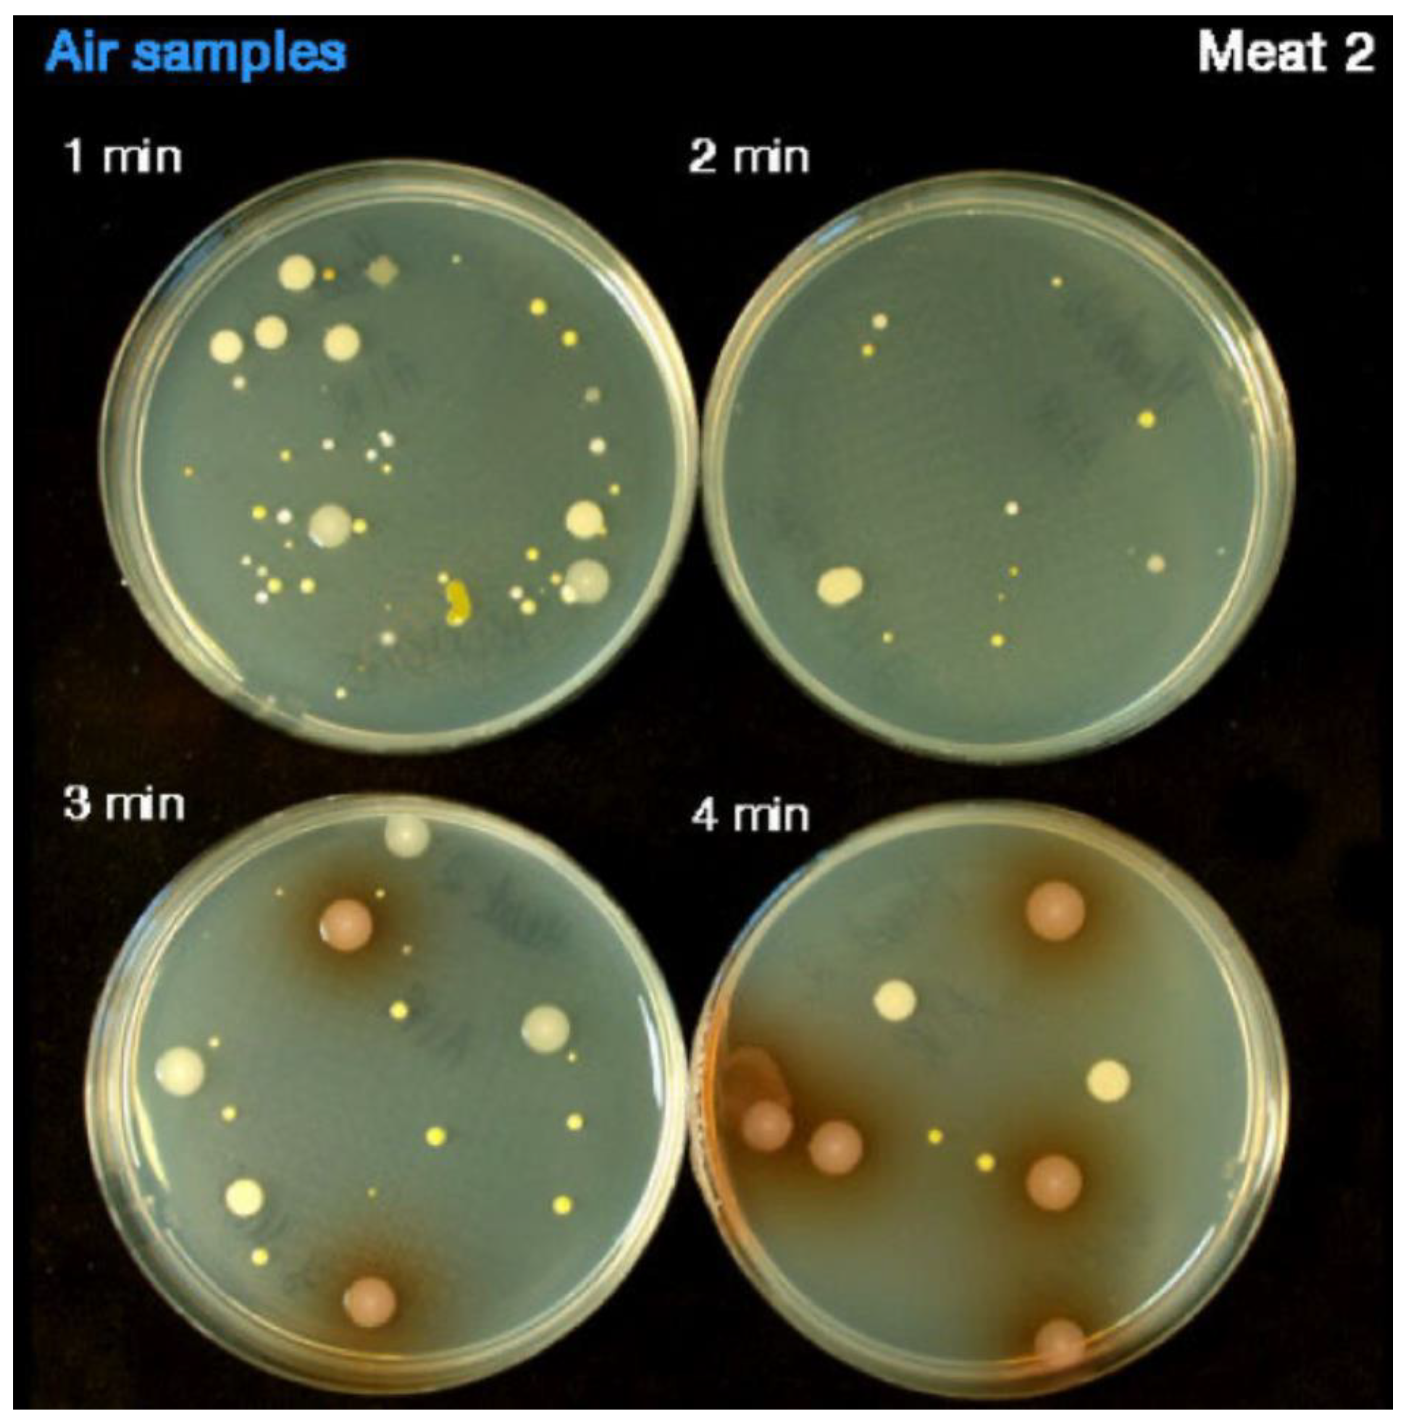

Submitted:
19 March 2025
Posted:
20 March 2025
You are already at the latest version
Abstract
Keywords:
1. Introduction
2. Design
3. Build Instructions
4. Operating Instructions
5. Validation
6. Conclusions
Supplementary Materials
Funding
Institutional Review Board Statement
Informed Consent Statement
Data Availability Statement
Conflicts of Interest
References
- Mainelis, G. Bioaerosol Sampling: Classical Approaches, Advances, and Perspectives. Aerosol Science and Technology 2020, 54, 496–519. [Google Scholar] [CrossRef] [PubMed]
- Datsugwai Mohammed, S.S.; Balogu, T.V. Sampling Methods for Airborne Microorganisms. In Aeromicrobiology; Elsevier, 2023; pp. 89–116 ISBN 9780323961226.
- Manibusan, S.; Mainelis, G. Passive Bioaerosol Samplers: A Complementary Tool for Bioaerosol Research. A Review. J Aerosol Sci 2022, 163, 105992. [Google Scholar] [CrossRef] [PubMed]
- Asefa, D.T.; Langsrud, S.; Gjerde, R.O.; Kure, C.F.; Sidhu, M.S.; Nesbakken, T.; Skaar, I. The Performance of SAS-Super-180 Air Sampler and Settle Plates for Assessing Viable Fungal Particles in the Air of Dry-Cured Meat Production Facility. Food Control 2009, 20, 997–1001. [Google Scholar] [CrossRef]
- Klees, A.G.; Ancrum, T. Environmental Monitoring Equipment: The Latest Is Cleanrooms & Isolator Technologies. Contract Pharma 2012. [Google Scholar]
- Setlhare, G.; Malebo, N.; Shale, K.; Lues, R. Identification of Airborne Microbiota in Selected Areas in a Health-Care Setting in South Africa. BMC Microbiol 2014, 14, 100. [Google Scholar] [CrossRef] [PubMed]
- Bali, R.; Sharma, P.; Nagrath, S.; Gupta, P. Microbial Isolations from Maxillofacial Operation Theatre and Its Correlation to Fumigation in a Teaching Hospital in India. J Maxillofac Oral Surg 2014, 13, 128–132. [Google Scholar] [CrossRef] [PubMed]
- Sandle, T. Real-Time Biological Particle Counting in Environmental Monitoring. European Pharmaceutical Review 2015, 20, 39–42. [Google Scholar]
- Whyte, W.; Eaton, T. Deposition Velocities of Airborne Microbecarrying Particles. European Journal of Parenteral and Pharmaceutical Sciences 2016, 21, 45–49. [Google Scholar]
- Taaffe, K.; Lee, B.; Ferrand, Y.; Fredendall, L.; San, D.; Salgado, C.; Shvorin, D.; Khoshkenar, A.; Reeves, S. The Influence of Traffic, Area Location, and Other Factors on Operating Room Microbial Load. Infect Control Hosp Epidemiol 2018, 39, 391–397. [Google Scholar] [CrossRef] [PubMed]
- Cobb, J. An Innovative Active Air Sampler for Continuous Viable Air Monitoring with Minimal Plate Changes. Clean Air and Containment Review 2020, 2020, 16–21. [Google Scholar]
- Adams, C.E.; Dancer, S.J. Dynamic Transmission of Staphylococcus Aureus in the Intensive Care Unit. Int J Environ Res Public Health 2020, 17, 2109. [Google Scholar] [CrossRef] [PubMed]
- Tan, K.S.; Chew, R.J.J.; Allen, P.F.; Yu, V.S.H. Aerosol-Generating Dental Procedures: A Reappraisal of Analysis Methods and Infection Control Measures. Journal of Hospital Infection 2021, 117, 81–88. [Google Scholar] [CrossRef] [PubMed]
- Dalmaso, G.; Campanella, A.; Lazzeri, P. Continuous and Effective Microbiological Air Monitoring in Critical Environments: A Comparison of Analytical Methodologies. PDA J Pharm Sci Technol 2020, 74, 446–455. [Google Scholar] [CrossRef] [PubMed]
- Settle Plates for Active and Passive Air Monitoring. Available online: https://www.sigmaaldrich.com/US/en/technical-documents/technical-article/microbiological-testing/viable-air-monitoring/settle-plates (accessed on 23 February 2025).
- Bowling, F.L.; Stickings, D.S.; Edwards-Jones, V.; Armstrong, D.G.; Boulton, A.J.M. Hydrodebridement of Wounds: Effectiveness in Reducing Wound Bacterial Contamination and Potential for Air Bacterial Contamination. J Foot Ankle Res 2009, 2. [Google Scholar] [CrossRef] [PubMed]



Disclaimer/Publisher’s Note: The statements, opinions and data contained in all publications are solely those of the individual author(s) and contributor(s) and not of MDPI and/or the editor(s). MDPI and/or the editor(s) disclaim responsibility for any injury to people or property resulting from any ideas, methods, instructions or products referred to in the content. |
© 2025 by the authors. Licensee MDPI, Basel, Switzerland. This article is an open access article distributed under the terms and conditions of the Creative Commons Attribution (CC BY) license (http://creativecommons.org/licenses/by/4.0/).